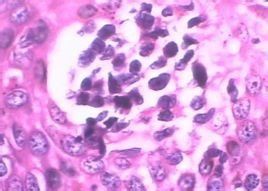
特異性陰道炎 特異性陰道炎

特異性陰道炎簡介
特異性陰道炎指的不是白色念珠菌、陰道毛滴蟲或淋病所引起的陰道炎,又稱為細菌性陰道炎。細菌性陰道病的常見症狀為陰道分泌物增多,呈膿性,漿液性,嚴重時分泌物有臭味。由於分泌物刺激尿道口,引起尿頻、尿急、尿痛,陰道內下墜感、灼熱,伴有盆腔不適及全身乏力。
特異性陰道炎發病原因
專家認為特異性陰道炎是由葡萄菌、鏈球菌、大腸桿菌及陰道嗜血桿菌等引起的陰道發炎。往往在陰道損傷、陰道內有子宮托或陰道塞、遺留棉球等異物,以及塗抹腐蝕性藥物、避孕用具或油膏、刺激性陰道沖洗等情況下,或因盆腔炎、附屬檔案炎、子宮內膜炎、流產及分娩子宮分泌物增多,長期子宮出血或陰道手術損傷等原因,使陰道的政策防禦功能遭到破壞,為病菌的生長繁殖創造條件而發生特異性陰道炎。
危害
1、病原體感染陰道致不孕
一些陰道炎可能是其他的病原體感染所致。比如解脲支原體、沙眼衣原體、抗生殖支原體等,都有可能發生陰道的感染。這種感染,不僅會發生不孕症,還很有可能發生胚胎停止發育、流產、死胎。因此,只要打算懷孕,就應該認真檢查,排除可能發生不孕的諸多因素。
2、陰道環境變化致不孕
陰道是性交和精液的容受器,陰道在正常情況下有一個相對安全的環境,有比較恆定的酸鹼度。當某些外陰、陰道器質性或功能性疾病發生時,陰道環境變化影響了正常精子的功能,從而導致不孕。這種適宜精子暫時存留、通過的環境,是非常重要的,一旦這種環境被破壞,就容易發生不孕。
3、陰道出血導致婦科病不孕
陰道出血是女性生殖器疾病最常見的症狀之一,病因是多方面的,除正常月經之外,當生殖器官發生炎症、病理性妊娠、內分泌疾患、外傷、腫瘤等情況時均可發生陰道出血。所以如果女性朋友出現陰道不正常出血時,應立即到醫院檢查,查明出血的原因,以免引發嚴重婦科病導致不孕發生。
治療方案
治療特異性陰道炎應針對引起的病因進行,如修補陰道損傷,清除陰道內異物,避免塗抹腐蝕性藥物及停止使用避孕用具及油膏,治療盆腔炎、附屬檔案炎及子宮內膜炎等疾病。並注意個人衛生,改善全身衛生情況。為治癒前禁止性生活。每天可用1%的乳酸或酸醋溶液做低壓陰道沖洗,改變陰道的酸鹼環境,抑制細菌生長。陰道壁內還可以塗抹抗生素粉,例如氯黴素、金黴素等等,每日一次,7-10次為一療程。
專家提示特異性陰道炎的治療要注意首先應該找出病因,然後再對症下藥,不能盲目的使用一些藥物進行擦洗和不科學的進行沖洗。
德國臭氧四聯治療
烏魯木齊都市麗人婦科醫院專家指出,德國臭氧四聯治療以其獨有的卓越療效風靡全球!該技術運用醫用純淨氣態臭氧快速有效治療附屬檔案炎等婦科炎症,只除病菌,不傷肌體,高效快捷,治癒率高,無任何副作用及後遺症,費用合理,深受女性患者青睞。都市麗人醫院引進“德國臭氧四聯治療”,是國際醫療上治療婦科炎症的“金標準”,它快速有效治療陰道炎、慢性盆腔炎、宮頸炎、細菌性陰道炎等,只除病菌,不傷肌體,高效快速的治療效果,深受女性患者的青睞。
德國臭氧四聯治療,給你“無炎”的關愛
•只殺病菌:臭氧活性強,分解原子氧能選擇性將有害病菌、病毒等快速殺滅,由於人體正常細胞量是“親氧”,細菌和病毒是“厭氧”的,因此該療法只殺有害細菌,不損有益菌。
•不傷肌膚:臭氧具有消炎、止疼功能,對人體正常組織無傷害,治療過程中無創傷、無痛苦、無流血,治癒後無疤痕,是真正意義上的無損傷綠色療法。
•保護更貼心:臭氧在殺菌同時形成開天闢地保護膜,妥帖保護患者有效預防感染。同時,藍氧淨療技術運用生物效應作用,不破壞陰道內酸鹼平衡,不影響陰道內的正常生理功能。
疾病護理
因為特異性陰道炎就是細菌性陰道炎,所以護理方式是一樣的。
由於非特異性陰道炎的發病主要與個人衛生以及相互感染等因素有關,故平時要注意清潔,防止致病菌的侵襲,杜絕傳染源,並增強體質,預防復發。
生活護理
1、注意個人衛生、保持外陰清潔乾燥;pH4弱酸配方的女性護理液更適合日常的清潔保養。勤洗換內褲,不與他人共用浴巾、浴盆,不穿尼龍或類似織品的內褲,患病期間用過的浴巾、內褲等均應煮沸消毒。
2、加強衛生宣傳,對工廠、機關、居民特別是集體宿舍的女工、女學生等,應定期普查、普治,以消滅傳染源。
3、治療期間禁止性交,或採用保險套以防止交叉感染。月經期間宜避免陰道用藥及坐浴。反覆發作者應檢查丈夫的小便及前列腺液,必要時反覆多次檢查,如為陽性應一併治療
飲食護理
飲食宜清淡,忌辛辣刺激,以免釀生濕熱或耗傷陰血。注意飲食營養,增強體質,以驅邪外出。
1、多食含有豐富的活性嗜酸乳桿菌的優酪乳,如雙歧桿菌的優酪乳、大豆低聚糖等,具有促使體內有益菌繁殖與生長、抑制有害菌生存的作用。
2、可食肉桂和蒜汁:使用這兩種食物作調料,能對抗感染,殺死造成尿道感染的白色念珠菌。
3、多食複合碳水化合物的食物:如全穀類、全麥、糙米和蔬菜等消化比較慢,不可能促進酵母菌的成長。
4、抗氧化永不嫌遲。多食富含抗氧化劑的食物,利於增強機體免疫力、抗感染,如維生素A、維生素C、維生素E以及微量元素鋅、鐵、鎂、銅和硒等屬於抗氧化物;還有一些諸如葡萄、柿子椒、苦瓜、西紅柿、芥末和花椰菜等食物以及薑黃和銀杏等草藥中含有生物類黃酮、番茄紅素、多酚類和花色素等,具有非常強的抗氧化作用。
但是,要儘量避免攝取富含單糖的食物。白色念珠菌靠單糖而繁衍,所以,要避免攝取富含單糖的食物和高量酵母的食物,如酒精飲料、蔗糖、糖蜜、甜菜、花生、乳酪、水果乾以及土豆、玉米、紅薯等含糖較高的食物
精神護理
非特異性陰道炎患者應穩定情緒,怕養性情,並根據患者的性格和發病誘因進行心理治療,加強鍛鍊,增強體質,提高自身免疫功能。積極消除誘發因素,及時治療生殖器官各種炎症。
運動調理
加強鍛鍊,增強體質。積極治療致病的原因,如陰道損傷、盆腔炎、子宮出血等,減少病原菌的生長繁殖。
預防
1、加強鍛鍊,增強體質:
積極治療致病的原因,如陰道損傷、盆腔炎、子宮出血等,減少病原菌的生長繁殖。注意合理套用廣譜抗生素及激素。糖尿病患者應控制好血糖,因為血糖過高時有利於黴菌生長,容易導致黴菌性陰道炎。
2、平時穿寬鬆透氣的衣褲:
避免緊身褲、化纖材料的衣褲。此外,應勤換內褲,內褲是棉質的,洗後在太陽下曬乾。因為黴菌對乾燥、紫外線以及化學製劑的抵抗力較強,但卻懼怕高溫。
此外,月經來潮時要注意外陰清潔,使用質量合格的衛生棉,注意避免細菌感染。衛浴設備須注意清潔,避免多人共享,以減少感染的幾率。陰道炎還可通過性生活感染,故在治療期間應避免性生活,必要時夫婦同時進行診治。
3、游泳注意衛生:
夏季里很多女性喜歡游泳,游泳池在給女性朋友帶來涼爽的同時,也帶來了很多陰道的“殺手”,而容易患上陰道炎。因此,女性朋友游泳時必須注意以下事項:
a、不要直接接觸公用椅凳。公共游泳池的更衣室通常都比較簡單,凳子、馬桶、儲物櫃都是公用的,儘管游泳館會定期清潔,但很難保證沒有細菌殘留。
b、月經期不能游泳。從女性的生理特點上來說,女性的陰道和外界是相通的,這就為細菌感染提供了可能,正因為女性在生理上有這樣的結構特點,游泳的時候才更要特別注意,否則很容易讓陰道受到感染,發生炎症。
4、飲食:
在飲食上須注意避免吃辛辣刺激性食物,可適度攝取含乳酸飲料,如優酪乳等,有利於維持陰道酸性環境,減少細菌感染。日常生活中以茶為飲品除預防和改善婦科炎症。像紫草、棱芯草、仙靈脾、藥仙茅就有消炎滅菌,清利濕熱,除異味,止癢,補氣養血的作用。
5、注意保持外陰清潔:
可常用清水清洗外陰,或遵醫囑用洗液清洗外陰,但要注意避免濫用洗液,儘量不要衝洗陰道,否則,會導致人體自然狀態和酸鹼平衡被破壞,增加陰道炎的發生率。同時,患病後切莫諱疾忌醫。很多女性患病後不願意找醫生,認為是難言之隱,但其實越早治療越能減輕疾病帶來的痛苦。